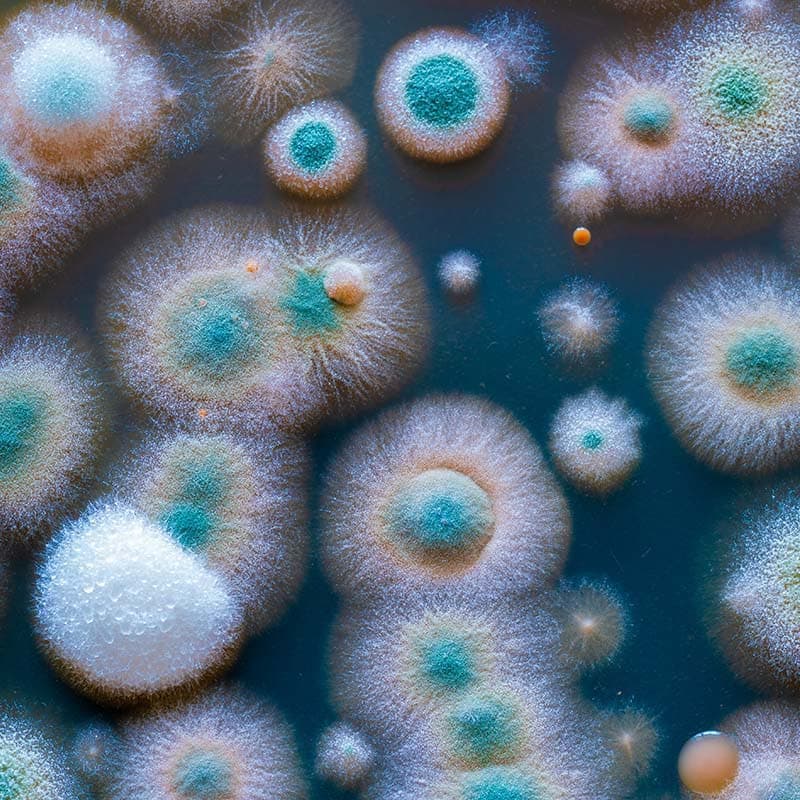

För att ge en bra upplevelse använder vi teknik som cookies för att lagra och/eller komma åt enhetsinformation. När du samtycker till dessa tekniker kan vi behandla data som surfbeteende eller unika ID:n på denna webbplats. Om du inte samtycker eller om du återkallar ditt samtycke kan detta påverka vissa funktioner negativt.
Den tekniska lagringen eller åtkomsten är absolut nödvändig för det legitima syftet att möjliggöra användningen av en specifik tjänst som uttryckligen begärts av abonnenten eller användaren, eller för det enda syftet att utföra överföring av en kommunikation över ett elektroniskt kommunikationsnät.
Den tekniska lagringen eller åtkomsten är nödvändig för det legitima syftet att lagra inställningar som inte efterfrågas av abonnenten eller användaren.
Den tekniska lagringen eller åtkomsten som används uteslutande för statistiska ändamål.
Den tekniska lagringen eller åtkomsten som används uteslutande för anonyma statistiska ändamål. Utan en stämningsansökan, frivillig efterlevnad från din Internetleverantörs sida, eller ytterligare register från en tredje part, kan information som lagras eller hämtas endast för detta ändamål vanligtvis inte användas för att identifiera dig.
Den tekniska lagringen eller åtkomsten krävs för att skapa användarprofiler för att skicka reklam, eller för att spåra användaren på en webbplats eller över flera webbplatser för liknande marknadsföringsändamål.